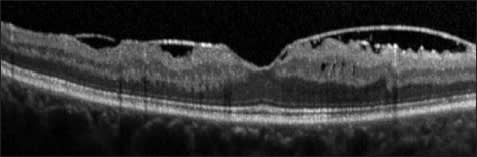
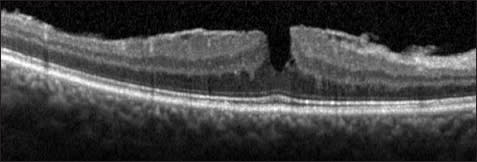

Spectral-domain Optical Coherence Tomography in the Evaluation and Management of Vitreomacular Interface Abnormalities
Andre J. Witkin, MD
Optical coherence tomography is an imaging technique that has revolutionized detection, treatment, and management of a number of macular disorders, including AMD, diabetic retinopathy, retinal vein occlusion, macular edema, and abnormalities of the vitreomacular interface.1
With the evolution of spectral-domain OCT systems, the ability of retinal physicians to evaluate the macular structure on a microscopic level has been even further enhanced. Current SD-OCT systems are capable of imaging the retina with an axial resolution of 3-7 µm and a transverse resolution of 15-20 µm.2
OCT is currently one of the most important tools in the diagnosis and management planning of vitreomacular interface abnormalities. A brief overview of OCT in the management of these disorders is presented here.
OCT OF THE VITREOMACULAR INTERFACE
Optical coherence tomography detects variations in optical properties within the vitreous and retina. While the posterior hyaloid remains attached to the macula earlier in life, it is difficult to visualize on OCT. However, as a person ages and the posterior hyaloid detaches from the macula, it becomes visible on OCT as a moderately reflective structure anterior to the retina.2
The progression of posterior vitreous detachment in otherwise normal eyes has been described and documented with OCT.3,4 First, the perifoveal hyaloid detaches from the macula, while remaining attached at the fovea (Figure 1). Next, the hyaloid detaches from the fovea but remains attached at the optic nerve head; the hyaloid is still visible on OCT at this stage as it remains close to the macula.

Figure 1. Normal eye. The posterior hyaloid is partially detached from the perifoveal region (arrow), with persistent attachment at the fovea and optic nerve. This is a normal stage of posterior vitreous detachment.
| Andre J. Witkin, MD, is on the faculty of the New England Eye Center, Tufts Medical Center Department of Ophthalmology in Boston, MA. He reports no financial interest in any products mentioned in this article. Dr. Witkin can be reached via e-mail at ajwitkin@gmail.com. |
Finally, the posterior hyaloid detaches from the optic nerve head, at which point the classic Weiss ring is observed on clinical examination; the hyaloid then disappears on OCT imaging as it pulls away from the macula.3,4 Therefore, the appearance of partial detachment of the hyaloid with persistent vitreomacular attachment or adhesion is often not pathologic.
In some individuals, however, the vitreous remains abnormally adherent to the macula. This abnormally strong adhesion can cause a variety of vitreomacular abnormalities that can affect the vision. The retina may become thickened or edematous secondary to persistent vitreomacular traction. As the posterior hyaloid separates from the fovea, it can lead to formation of partial or fullthickness macular holes.4
Secondary preretinal fibrotic membranes may form on the surface of the macula and cause distortion of the macular contour. In some patients with abnormal vitreomacular adhesion, the posterior hyaloid splits into multiple layers; this is termed vitreoschisis, and it can be visualized using OCT.5
Optical coherence tomography is used to differentiate, manage, and follow disorders of the vitreomacular interface. In addition, certain preoperative characteristics, particularly the continuity of various photoreceptor layers visible on OCT, have been correlated with postoperative visual results in a variety of vitreomacular interface disorders.6-14
Postoperatively, particularly after macular hole repair, photoreceptor abnormalities can also be visualized with high-resolution OCT. Occasionally, similar foveal photoreceptor defects may be seen after spontaneous release of vitreofoveal traction.15,16
VITREOMACULAR TRACTION SYNDROME
The formation of retinal thickening or edema secondary to vitreous traction at the macula is termed vitreomacular traction (VMT) syndrome. A variety of patterns of VMT can be visualized on OCT. Attachments of the posterior hyaloid can be broad-based or focal.
Broad-based adhesions typically have been defined as 1,500 µm or more on OCT and typically cause diffuse retinal thickening; they can appear similar to ERMs, and there may be some overlap between ERMs and broad-based vitreomacular traction (Figure 2).

Figure 2. Vitreomacular traction syndrome. This is an example of a broad-based vitreous attachment to the macula (>1,500 -m in width). The patient has a thickened macula with a foveal cystic space present. The chief complaint was metamorphopsia in this patient
Focal adhesions of the vitreous to the macula cause more distortion of foveal anatomy, including foveal cystic areas and occasionally formation of subretinal fluid.17-19 Focal adhesion to the fovea likely leads to a greater affect on visual acuity, while broad-based adhesions typically affect VA less but can cause more metamorphopsia.
Recently, the term vitreomacular adhesion (VMA) has been used to describe focal adhesion of the posterior hyaloid to the fovea. When this VMA causes visual distortion, it is termed pathologic VMA.4
The natural history of pathologic VMA has been described using OCT. At first, subtle distortions of foveal contour may be the only apparent finding.20 Next, an inner retinal cystic space may form; this can sometimes be seen as a stage 1 macular hole on examination, as described by Gass.21
Often, the vitreous will separate spontaneously; however, a partial or fullthickness macular hole can sometimes form.22 Persistent foveal traction can also lead to macular edema, sometimes with formation of subretinal fluid.
Certain characteristics on OCT may help predict visual and anatomic outcomes of vitrectomy for vitreomacular traction syndrome. Broad-based vitreous adhesions tend to have less of a visual benefit after surgical repair, while patients with cystoid macular edema tend to do better visually.23-26
We also described a small subset of patients who had a lamellar separation or schisis of macular layers; these patients seemed to have a higher incidence of partial- or full-thickness macular hole formation postoperatively.27 However, the numbers in all of these studies are small, and no definitive conclusions regarding preoperative prognostic indicators on OCT can be made.
EPIRETINAL MEMBRANES
Epiretinal membranes are accumulations of contractile fibrous tissue on the surface of the retina. They can be primary (or idiopathic), usually a result of PVD and subsequent fibroglial proliferation or they can be secondary, due to uveitis, proliferative vitreoretinopathy, or other coexisting retinal pathologies.28
On OCT, ERMs appear as a highly reflective band of tissue on the surface of the retina. They can be broadly adherent to the retina, sometimes making them difficult to visualize on OCT. The transition from time-domain to spectral-domain OCT has been particularly beneficial in visualizing ERMs with broad attachments to the macula.29
Other ERMs are separated from the retina and have multiple focal attachments to the macula; these membranes are more easily discernible on OCT (Figure 3).28-30 It has been postulated that the edge of the ERM may be identified using SD-OCT and be used in operative planning.31
Figure 3. Epiretinal membrane. A highly reflective ERM with focal attachments to the macula is evident.
Epiretinal membranes cause thickening of the retina, which can be visualized using OCT. On SD-OCT, inner retina thickening is highly variable between patients, and a thicker retina has been associated with worse vision in patients with ERM.32 Distortion of the inner retinal layers on SD-OCT have also been correlated with metamorphopsia in patients with ERM.33
Disruption of several photoreceptor layers on SD-OCT has been correlated with pre- and postoperative visual acuity before and after vitrectomy for ERM. Preoperative disruptions of the photoreceptor inner/outer segment junction are associated with poorer visual acuity results postoperatively.6-9 After surgery, disruption of the IS/OS junction, as well as the cone outer segment line, have been associated with worse visual acuities.6-10
In contrast, central foveal thickness on OCT does not correlate as significantly with postoperative visual acuity. Disruptions of the external limiting membrane on SD-OCT have also been associated with worse visual acuity before and after vitrectomy for ERM.11
FULL-THICKNESS MACULAR HOLES
Optical coherence tomography has revolutionized the diagnosis and the understanding of full-thickness macular holes. With the advent of OCT, it is now evident that macular holes form from focal adhesions of the vitreous to the fovea. As vitreofoveal traction persists, a foveal pseudocyst is formed.21,22 The fovea begins to separate from the RPE as it is pulled; focal detachment of the fovea causes a yellow dot, or stage 1 macular hole, to appear on clinical examination.22
The outer retinal pseudocyst then expands until only a “roof” of retinal tissue is present at the fovea (Figure 4). Finally, the inner retina “roof” opens, and a stage 2 macular hole forms.22, 34, 35 The visualization of adherent posterior hyaloid membrane is aided with OCT. After separation of the posterior hyaloid from the fovea, an operculum or pseudo-operculum may be visualized on OCT.

Figure 4. Foveal pseudocyst. This patient had decreased visual acuity and a yellow foveal ring on examination (stage lB macular hole). A foveal pseudocyst is evident, with a “roof” of tissue covering a nearly full-thickness macular defect. Persistent traction of the posterior hyaloid to the fovea is evident.
It is known that vitreomacular interface abnormalities are commonly bilateral. Partial vitreous separation with persistent vitreofoveal adhesion on OCT in the fellow eyes of patients with full-thickness macular holes has been shown to be associated with a higher chance of developing a macular hole in that eye; Chan and associates termed this OCT finding a “stage 0” macular hole (Figure 5).36

Figure 5. Stage O macular hole. This is the fellow eye of a patient who had a fullthickness macular hole in the opposite eye. A partial vitreous separation with persistent vitreofoveal attachment is evident. This configuration confers a higher risk for future macular hole formation in fellow eyes of macular holes.
In addition, Kumagai and colleagues described a higher incidence of “foveal deformation” secondary to macular PVD on SD-OCT of fellow eyes of patients with full-thickness macular holes, likely due to disruption of foveal contour after separation of the abnormally adherent posterior hyaloid from the fovea.37
After vitrectomy, ultrahigh-resolution and SD-OCT have demonstrated outer foveal photoreceptor disruptions; a clear cystic space in the outer retinal layers of the fovea is often present (Figure 6). Over time, these disruptions get smaller, although often they do not disappear completely.38- 41 Similar outer retinal defects may be seen after spontaneous closure of macular holes.15,16,22 The size of disruptions of the IS/OS junction measured on SD-OCT is correlated with visual acuity after macular hole repair.12-14

Figure 6. Full-thickness macular hole. The top is a picture of a stage 2 macular hole. Persistent vitreofoveal traction is apparent. On the bottom is an OCT image of the same patient three months after surgical repair. Note a small cystic space in the outer layers of the fovea. The fovea is enlarged, and the outer retinal layers are labeled: ELM (external limiting membrane); IS/OS (photoreceptor inner/outer segment junction); and PROS (photoreceptor outer segments).
Similarly, integrity and length of other outer retinal line on SD-OCT, the cone outer segment tips (COST) line and the external limiting membrane have been correlated with postoperative visual acuity after repair of macular hole.14, 42 Some patients have slightly hyper-reflective tissue present at the site of hole closure visualized with ultrahigh resolution and SD-OCT; this may represent glial tissue that has formed at the edges of the hole. These patients often have larger macular holes preoperatively.41, 43
After macular hole repair, SD-OCT may be used to assess macular hole closure as soon as one day after surgery. Macular hole closure can be detected through a gas bubble; however, this is not always possible due to optical aberrations. The Watzke-Allen test may still be a more feasible way to measure hole closure in the immediate postoperative period.44
MACULAR PSEUDOHOLES AND LAMELLAR MACULAR HOLES
Lamellar macular holes and macular pseudoholes have classically been described as separate entities. Lamellar holes were originally thought to be due to an abortive process of full-thickness macular hole formation or secondary to macular edema, while macular pseudoholes have typically been defined as occurring from the creation of the appearance of a macular hole due to circumferential contraction of a preformed ERM.44, 45
However, with the use of OCT, lamellar macular holes are much more evident than on clinical examination. A lamellar hole can now be redefined using OCT criteria as: (1) an irregular foveal contour; (2) a break in the inner fovea; (3) separation of the inner from the outer foveal retinal layers, leading to an intraretinal split; and (4) absence of a fullthickness foveal defect with intact photoreceptors posterior to the area of foveal dehiscence (Figure 7).45

Figure 7. Lamellar macular hole. A lamellar hole is evident by the following criteria: an irregular foveal contour, a break in the inner fovea, separation of the inner from the outer foveal retinal layers leading to an intraretinal split, and absence of a full-thickness foveal defect with intact photoreceptors posterior to the area of foveal dehiscence. A thickened ERM is evident lining the borders of the foveal defect (arrow)
In the age of OCT, the term “pseudohole” may be used to describe the appearance of a macular hole on examination without a full-thickness defect on OCT. Lamellar macular hole may then be classified as a subtype of pseudohole. The more classic macular pseudohole secondary to ERM contraction appears as a steepening of foveal borders on OCT, usually without separation of intraretinal layers (Figure 8).45,46
Figure 8. Macular pseudohole. A broadly adherent ERM is evident. The contour of the fovea is steepened by contraction of the membrane, leading to the appearance of the macular hole on clinical examination. However, there is no loss of tissue or break in the fovea.
It is now evident that the majority of lamellar holes also have associated ERMs; many lamellar holes may therefore form secondary to horizontal or tangential traction from the posterior hyaloid and/or an ERM.47 Ultrahigh-resolution and SD-OCT studies show an unusual “thickened” or “dense” appearance of many of these ERMs, which may represent an abnormally thickened posterior hyaloid or hyaloid remnants; on histopathology, these “dense” membranes contain cortical vitreous fibrils.45
Indeed, many lamellar holes that require surgery have an adherent posterior hyaloid that requires peeling. Additionally, the thickened or dense membranes are often tightly adherent to the macula and have a yellowish appearance clinically.48
Most commonly, lamellar macular holes are a stable condition; however, a small number of patients are symptomatic and opt for surgical repair.49 To date, no preoperative OCT characteristics have been shown to be predictive of surgical outcomes with repair of lamellar macular holes. Many authors have shown favorable results; however, in some studies, there were several patients who formed fullthickness macular holes postoperatively and required repeat surgery.50-54
As with other vitreomacular disorders, the integrity of the photoreceptor IS/OS junction has been correlated with visual acuity in lamellar macular holes and macular pseudoholes. Patients with foveal disruptions of the IS/OS line tend to have worse visual acuities.55
VITREOMACULAR INTERFACE ABNORMALITIES ASSOCIATED WITH OTHER RETINAL DISEASES
Other ocular and retinal diseases, including high myopia, AMD, and diabetic retinopathy, have been associated with abnormalities of the vitreomacular interface. In pathologic myopia, patients often develop a separation or schisis of macular layers; this appearance has been termed myopic foveoschisis, and OCT has been beneficial in diagnosis of the condition (Figure 9). Using SD-OCT, it seems that the inner retinal layers are contracted by either a tight posterior hyaloid or ILM.56-58

Figure 9. Myopic foveoschisis. This is a patient with high myopia and an ERM. Foveoschisis is evident, as the inner retinal layers separate from the outer retinal layers
In some patients, a partial or full-thickness macular hole may be detected on OCT while nearly invisible on clinical examination due to chorioretinal degeneration. Other patients have foveal detachment from the wall of the eye. In some patients with myopic foveoschisis, paravascular microholes may also be evident.59 In other patients, tightening of the ILM causes it to detach from the macula; OCT can be used to detect ILM detachment and to potentially plan surgical technique.60
In diabetic retinopathy, ERM and VMT may be visualized using OCT in some patients with persistent DME. Visual acuity results of membrane peeling for DME have been mixed; however, visual acuities tend to improve if vitreoretinal interface abnormalities are detected on OCT.61,62
In neovascular AMD, OCT has shown that there is a higher incidence of vitreomacular adhesions than in eyes without neovascular AMD. In some patients with refractory AMD, despite intravitreal injections of anti-VEGF medications, vitreomacular traction may be evident on OCT, and surgical repair can lead to resolution of fluid on OCT and improvement of vision.63,64
CONCLUSION
Optical coherence tomography has become a vital component in diagnosing and understanding the vitreomacular interface. SD-OCT has further enhanced visualization of the vitreomacular interface, as well as the effects of vitreomacular interface abnormalities on other intraretinal microstructures, particularly the photoreceptors.
It is clear that a number of macular diseases that were previously thought to be separate entities are now known to have similar pathogeneses and can sometimes appear similar on OCT. Microstructural characteristics on SD-OCT can aid in surgical planning by allowing precise visualization of the vitreomacular interface. Certain characteristics of the outer retina on SD-OCT can also be useful in predicting pre- and postoperative visual acuities. RP
REFERENCES
1. Huang D, Swanson EA, Lin CP, et al. Optical coherence tomography. Science. 1991;254:1178-1181.2. Witkin AJ, Ip M, Duker JS. Optical coherence tomography. In: Duane's Clinical Ophthalmology. Tasman W, Jaeger EA, eds. Philadelphia, PA; Lippincott Williams & Wilkins; 2012.
3. Uchino E, Uemura A, Ohba N. Initial stages of posterior vitreous detachment in healthy eyes of older persons evaluated by optical coherence tomography. Arch Ophthalmol. 2001;119:1475-1479.
4. Johnson MW. Posterior vitreous detachment: evolution and complications of its early stages. Am J Ophthalmol. 2010;149:371-382.
5. Gupta P, Yee KM, Garcia P, et al. Vitreoschisis in macular diseases. Br J Ophthalmol. 2011;95:376-380.
6. Suh MH, Seo JM, Park KH, Yu HG. Associations between macular findings by optical coherence tomography and visual outcomes after epiretinal membrane removal. Am J Ophthalmol. 2009;147:473-480.
7. Mitamura Y, Hirano K, Baba T, Yamamoto S. Correlation of visual recovery with presence of photoreceptor inner/outer segment junction in optical coherence images after epiretinal membrane surgery. Br J Ophthalmol. 2009;93:171-175.
8. Inoue M, Morita S, Watanabe Y, et al. Inner segment/outer segment junction assessed by spectral-domain optical coherence tomography in patients with idiopathic epiretinal membrane. Am J Ophthalmol. 2010;150:834-839.
9. Massin P, Allouch C, Haouchine B, et al. Optical coherence tomography of idiopathic macular epiretinal membranes before and after surgery. Am J Ophthalmol. 2000;130:732-739.
10. Shimozono M, Oishi A, Hata M, et al. The significance of cone outer segment tips as a prognostic factor in epiretinal membrane surgery. Am J Ophthalmol. 2012;153:698-704.
11. Theodossiadis PG, Theodossiadis GP, Charonis A, et al. The photoreceptor layer as a prognostic factor for visual acuity in the secondary epiretinal membrane after retinal detachment surgery: imaging analysis by spectral-domain optical coherence tomography. Am J Ophthalmol. 2011;151:973-980.
12. Christensen UC, KrØyer K, Sander B, et al. Macular morphology and visual acuity after macular hole surgery with or without internal limiting membrane peeling. Br J Ophthalmol. 2010;94:41-47.
13. Ruiz-Moreno JM, Lugo F, Montero JA, Piñero DP. Restoration of macular structure as the determining factor for macular hole surgery outcome. Graefes Arch Clin Exp Ophthalmol. 2012 Feb 23. [Epub ahead of print]
14. Ooka E, Mitamura Y, Baba T, et al. Foveal microstructure on spectral-domain optical coherence tomographic images and visual function after macular hole surgery. Am J Ophthalmol. 2011;152:283-290.
15. Zambarakji HJ, Schlottmann P, Tanner V, Assi A, Gregor ZJ. Macular micro holes: pathogenesis and natural history. Br J Ophthalmol. 2005;89:189-193.
16. Witkin AJ, Wojtkowski M, Reichel E, et al. Photoreceptor disruption secondary to posterior vitreous detachment as visualized using high-speed ultrahigh-resolution optical coherence tomography. Arch Ophthalmol. 2007;125: 1579-1580.
17. Yamada N, Kishi S. Tomographic features and surgical outcomes of vitreomacular traction syndrome. Am J Ophthalmol. 2005;139:112-117.
18. Koizumi H, Spaide RF, Fisher YL, et al. Three-dimensional evaluation of vitreomacular traction and epiretinal membrane using spectral-domain optical coherence tomography. Am J Ophthalmol. 2008;145:509-517.
19. Spaide RF, Wong D, Fisher Y, et al. Correlation of vitreous attachment and foveal deformation in early macular hole states. Am J Ophthalmol. 2002;133: 226-229.
20. Witkin AJ, Ko TH, Fujimoto JG, et al. Vitreofoveal attachment causing metamorphopsia: an ultrahigh-resolution optical coherence tomography finding. Retina. 2006;26:1085-1087.
21. Haouchine B, Massin P, Gaudric A. Foveal pseudocyst as the first step in macular hole formation. Ophthalmology. 2001;108:15-22.
22. Takahashi A, Nagaoka T, Ishiko S, Kameyama D, Yoshida A. Foveal anatomic changes in a progressing stage 1 macular hole documented by spectral-domain optical coherence tomography. Ophthalmology. 2010;117:806-810.
23. Sonmez K, Capone A Jr, Trese MT, Williams GA. Vitreomacular traction syndrome: impact of anatomical configuration on anatomical and visual outcomes. Retina. 2008;28:1207-1214.
24. Yamada N, Kishi S. Tomographic features and surgical outcomes of vitreomacular traction syndrome. Am J Ophthalmol. 2005;139:112-117.
25. Do DV, Cho M, Nguyen QD, et al. The impact of optical coherence tomography on surgical decision making in epiretinal membrane and vitreomacular traction. Trans Am Ophthalmol Soc. 2006;104:161-166.
26. Johnson MW. Tractional cystoid macular edema: a subtle variant of the vitreomacular traction syndrome. Am J Ophthalmol. 2005;140:184-192.
27. Witkin AJ, Patron ME, Castro LC, et al. Anatomic and visual outcomes of vitrectomy for vitreomacular traction syndrome. Ophthalmic Surg Lasers Imaging. 2010;41:425-431.
28. Mori K, Gehlbach PL, Sano A, Deguchi T, Yoneya S. Comparison of epiretinal membranes of differing pathogenesis using optical coherence tomography. Retina. 2004;24:57-62.
29. Nigam N, Bartsch DU, Cheng L, et al. Spectral domain optical coherence tomography for imaging ERM, retinal edema, and vitreomacular interface. Retina. 2010;30:246-253.
30. Michalewski J, Michalewska Z, Cisiecki S, Nawrocki J. Morphologically functional correlations of macular pathology connected with epiretinal membrane formation in spectral optical coherence tomography (SOCT). Graefes Arch Clin Exp Ophthalmol. 2007;245:1623-1631.
31. Hirano Y, Yasukawa T, Ogura Y. Optical coherence tomography guided peeling of macular epiretinal membrane. Clin Ophthalmol. 2010;5:27-29.
32. Koo HC, Rhim WI, Lee EK. Morphologic and functional association of retinal layers beneath the epiretinal membrane with spectral-domain optical coherence tomography in eyes without photoreceptor abnormality. Graefes Arch Clin Exp Ophthalmol. 2012;250:491-498.
33. Watanabe A, Arimoto S, Nishi O. Correlation between metamorphopsia and epiretinal membrane optical coherence tomography findings. Ophthalmology. 2009;116:1788-1793.
34. Niwa H, Terasaki H, Ito Y, Miyake Y. Macular hole development in fellow eyes of patients with unilateral macular hole. Am J Ophthalmol. 2005;140:370-375.
35. Smiddy WE, Flynn HW Jr. Pathogenesis of macular holes and therapeutic implications. Am J Ophthalmol. 2004;137:525-537.
36. Chan A, Duker JS, Schuman JS, Fujimoto JG. Stage 0 macular holes: observations by optical coherence tomography. Ophthalmology. 2004;111:2027-2032.
37. Kumagai K, Hangai M, Larson E, Ogino N. Vitreoretinal interface and foveal deformation in asymptomatic fellow eyes of patients with unilateral macular holes. Ophthalmology. 2011;118:1638-1644.
38. Mahmoud TH, McCuen BW 2nd. Natural history of foveolar lucencies observed by optical coherence tomography after macular hole surgery. Retina. 2007;27: 95-100.
39. Punjabi OS, Flynn HW, Legarreta JE, et al. Documentation by spectral domain OCT of spontaneous closure of idiopathic macular holes. Ophthalmic Surg Lasers Imaging. 2007;38:330-332.
40. Michalewska Z, Michalewski J, Cisiecki S, et al. Correlation between foveal structure and visual outcome following macular hole surgery: a spectral optical coherence tomography study. Graefes Arch Clin Exp Ophthalmol. 2008; 246:823-830.
41. Ko TH, Witkin AJ, Fujimoto JG, et al. Ultrahigh-resolution optical coherence tomography of surgically closed macular holes. Arch Ophthalmol. 2006;124: 827-836.
42. Itoh Y, Inoue M, Rii T, Hiraoka T, Hirakata A. Correlation between length of foveal cone outer segment tips line defect and visual acuity after macular hole closure. Ophthalmology. 2012 Mar 14. [Epub ahead of print]
43. Oh J, Yang SM, Choi YM, Kim SW, Huh K. Glial proliferation after vitrectomy for a macular hole: a spectral domain optical coherence tomography study. Graefes Arch Clin Exp Ophthalmol. 2012 May 24. [Epub ahead of print]
44. Gass JD. Lamellar macular hole: a complication of cystoid macular edema after cataract extraction: a clinicopathologic case report. Trans Am Opthalmol Soc. 1975;73:230-250.
45. Witkin AJ, Ko TH, Fujimoto JG, et al. Redefining lamellar holes and the vitreomacular interface: an ultrahigh-resolution optical coherence tomography study. Ophthalmology. 2006;113:388-397.
46. Chen JC, Lee LR. Clinical spectrum of lamellar macular defects including pseudoholes and pseudocysts defined by optical coherence tomography. Br J Ophthalmol. 2008;92:1342-1346.
47. Michalewski J, Michalewska Z, Dzi gielewski K, Nawrocki J. Evolution from macular pseudohole to lamellar macular hole - spectral domain OCT study. Graefes Arch Clin Exp Ophthalmol. 2011;249:175-178.
48. Parolini B, Schumann RG, Cereda MG, Haritoglou C, Pertile G. Lamellar macular hole: a clinicopathologic correlation of surgically excised epiretinal membranes. Invest Ophthalmol Vis Sci. 2011;52:9074-9083.
49. Bottoni F, Deiro AP, Giani A, et al. The natural history of lamellar macular holes: a spectral domain optical coherence tomography study. Graefes Arch Clin Exp Ophthalmol. 2012 May 9. [Epub ahead of print]
50. Garretson BR, Pollack JS, Ruby AJ, et al. Vitrectomy for a symptomatic lamellar macular hole. Ophthalmology. 2008;115:884-886.
51. Michalewski Z, Michalewski J, Odrobina D, et al. Surgical treatment of lamellar macular holes. Graefes Arch Clin Exp Ophthalmol. 2010;248:1395-1400.
52. Engler C, Schaal KB, Hoh AE, et al. Surgical treatment of lamellar macular hole. Ophthalmologe. 2008;105:836-839.
53. Casparis H, Bovey EH. Surgical treatment of lamellar macular hole associated with epimacular membrane. Retina. 2011;31:1783-1790.
54. Witkin AJ, Castro LC, Reichel E, et al. Anatomic and visual outcome of vitrectomy for lamellar macular holes. Ophthalmic Surg Lasers Imaging. 2010;5:1-7.
55. Michalewska Z, Michalewski J, Odrobina D, Nawrocki J. Non-full-thickness macular holes reassessed with spectral domain optical coherence tomography. Retina. 2012;32:922-929.
56. VanderBeek BL, Johnson MW. The diversity of traction mechanisms in myopic traction maculopathy. Am J Ophthalmol. 2012;153:93-102.
57. Fang X, Weng Y, Xu S. Optical coherence tomographic characteristics and surgical outcome of eyes with myopic foveoschisis. Eye. 2009;23: 1336-1342.
58. Takano M, Kishi S. Foveal retinoschisis and retinal detachment in severely myopic eyes with posterior staphyloma. Am J Ophthalmol. 1999;128:472-476.
59. Sayanagi K, Morimoto Y, Ikuno Y, Tano Y. Spectral-domain optical coherence tomographic findings in myopic foveoschisis. Retina. 2010;30:623-628.
60. Sayanagi K, Ikuno Y, Tano Y. Tractional internal limiting membrane detachment in highly myopic eyes. Am J Ophthalmol. 2006;142:850-852.
61. Gandorfer A, Rohleder M, Grosselfinger S, et al. Epiretinal pathology of diffuse diabetic macular edema associated with vitreomacular traction. Am J Ophthalmol. 2005;139:638-652.
62. Diabetic Retinopathy Clinical Research Network Writing Committee; Haller JA, Qin H, et al. Vitrectomy outcomes in eyes with diabetic macular edema and vitreomacular traction. Ophthalmology. 2010;117:1087-1093.
63. Krebs I, Brannath W, Glittenberg C, et al. Posterior vitreomacular adhesion: a potential risk factor for exudative age-related macular degeneration? Am J Ophthalmol. 2007;144:741-746.
64. Lee SJ, Lee CS, Koh HJ. Posterior vitreomacular adhesion and risk of exudative age-related macular degeneration: paired eye study. Am J Ophthalmol. 2009;147:621-626.








